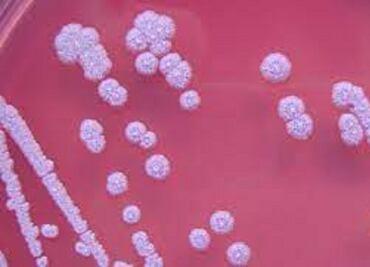

Se han confirmado tres casos de personas con la enfermedad y se declaró endemia
Se han confirmado tres casos de personas con la enfermedad y se declaró endemia

¿El coronavirus sigue siendo una pandemia, o es ya una endemia que permita ver la luz al final del túnel? ¿O se trata más bien de una sindemia? Y, en última instancia, ¿cuál es la diferencia? Acá te explicamos todo lo que hay que saber al respecto


Profesor de la Universidad de Oxford advierte sobre los peligros y confusiones que la palabra "endemia" puede generar

¿Estamos cerca de comenzar una era endémica de covid? Y ¿qué significará esto para nuestras vidas?